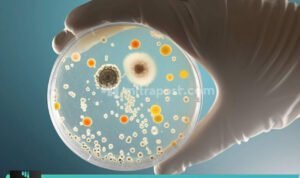

Demak, Mitrapost.com – Dalam rangka memeriahkan Hari Bhayangkara ke-74, Polres Demak gelar serangkaian lomba. Salah satunya adalah lomba keterampilan penggunaan tongkat dan borgol, Rabu (24/6/2020).
Bertempat di Aula Pendopo Parama Satwika, lomba tersebut dimeriahkan oleh 4 kelompok peserta, yaitu dari Satpol-pp, Polhut, Polsuspas dan Satpam.
Kapolres Demak, AKBP R. Fidelis Purna Timoranto menjelaskan, Satpol-pp, Polhut, Polsuspas dan Satpam adalah mitra polisi yang melaksanakan tugas kepolisian terbatas. Oleh sebab itu, Polres Demak mengajak untuk me-refresh kembali cara penggunaan tongkat dan borgol dalam bentuk perlombaan.
“Tujuan digelarnya lomba ini selain untuk meningkatkan keterampilan para peserta dari Satpam, Satpol PP, Polhut dan Polsuspas dalam menggunakan borgol dan tongkat juga untuk meningkatkan sinergitas Polri dengan para peserta itu sendiri,” kata Fidel.
Baca juga: Siswa Tidak Mampu, Mendapatkan Fasilitas dari Sekolah Selama KBM Online
Ketua panitia, AKP Mulyono menjelaskan dalam lomba peragaan penggunaan tongkat dan borgol tersebut kriteria yang dinilai dewan juri meliputi kerapian, kekompakan, semangat dan penguasaan materi.
“Siapapun yang terpilih sebagai juara harus dipertahankan dan ditingkatkan. Bagi yang tidak terpilih sebagai juara harus tetap semangat dan belajar dari kekurangan,” ungkapnya.
Dalam lomba tersebut, Satpol-pp Kabupaten Demak menjadi juara pertama, diikuti Polsuspas Demak dan Polhut KPH Semarang sebagai juara dua dan juara tiga. Sedangkan juara empat diberikan kepada Satpam PT. Delta Dunia Sandang Textile Demak. (*)
Baca juga:
- Peringati Hari Bhayangkara Ke-74, Polres Demak Gelar Lomba Tahfidz Qur’an
- Belajar Otodidak, Pengrajin Kapal Soyo Hasilkan 3 Sampai 5 Miliar
- Sebanyak 7 Orang Reaktif Covid-19, Kini Dikarantina di Wisma Hasanah Demak
Jangan lupa kunjungi media sosial kami, di facebook, twitter dan instagram
Redaktur : Ulfa PS
Wartawan